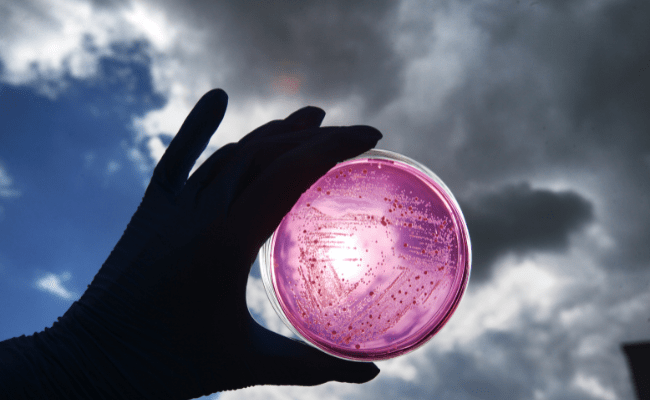

FAVEA
Zdraví je u nás na prvním místě. Vyrábíme inovativní, bezpečné doplňky stravy zvyšující kvalitu života.
V rámci obchodních vztahů se řídíme heslem „grow together“. Naše zákazníky si pečlivě vybíráme a jsou pro nás plnohodnotnými partnery nejen v obchodu, ale i v dalších odborných oblastech. FAVEA je synonymem vysoké kvality, spolupráce a rovných příležitostí a takto ji vnímají i „FAVEÁCI“.
FAVEA je o lidech, kteří tvoří nezaměnitelnou firemní kulturu a zdravého ducha. Přidat se do našeho týmu znamená pomáhat lidem kdekoliv na světě, aby se cítili maximálně komfortně a bezpečně.
Z pohledů inovací nejsme žádní zelenáči 😊. Jdeme cestou globálních trendů a díky naší unikátní technologii jsme firmou, která si v oblasti nutraceutik dokáže držet ten nejpřísnější standard.

Soustředíme se na lidi a jejich hodnoty. Jsou to právě oni, kdo posouvají FAVEA kupředu.
Martina Pavlová
CEO

Jak se mění svět, měníme se i my
Díky B2B partnerům jsou naše produkty v téměř 30 zemí světa. Jsme smluvní výrobci technologických řešení proto pro nás není problém reagovat na neustále se měnící tržní požadavky zákazníků. Inovace a návrh nových zajímavých řešení jsou pro FAVEA velkou výzvou.
Investujeme do špičkových technologií (jsme jediní v ČR a druzí v Evropě, kdo dokáže zkombinovat více produktů v jedné kapsli), udáváme trendy v oboru.
Cíl? Dotáhnout světovou špičku, které v mnoha řešeních šlapeme na paty!
Máme k sobě blízko
FAVEA přitahuje lidi s otevřenou myslí, schopné zasmát se vlastní chybě a okamžitě ji běžet napravit. Ve výrobě i v kancelářích potkáš usměvavé „bílé pláště“ a když se tě ředitelka na chodbě zeptá, jak to jde, neboj se říct pravdu.
V našem kmeni pracují specialisté výroby, manažeři kvality, mikrobiologové, logistici, obchodníci, ekonomové, technologové i markeťáci. Všichni tak, aby společně naplňovali firemní vize a zároveň se pořád učili. Není tajemstvím, že odpoledne sedají na kola, vyrážejí na pivo, zdolávají beskydské kopce.
Jsme pořád v pohybu
Kdo hledá teplé místečko v závětří, ve FAVEA pohoří. Aktivním kolegům ale otevíráme dveře s radostí.
Podporujeme vzdělávání, růst odbornosti a rozvoj, ceníme si přínosných inovací. Žádný nápad, který přineseš, nezapadne. Probrat je klidně můžeme během teambuildingu nebo na koupališti. A když dorazíš na oblíbený Vánoční večírek, potkáš se i s kolegyněmi na rodičovské dovolené.
V kině se u nás nemluví, ledaže se rozhodneš pustit kolegům sestřih ze zajímavé dovolené nebo uspořádat malý stand-up.